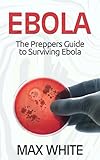
Ebola: The Preppers Guide to Surviving Ebola (Ebola, Ebola Virus, Ebola Survival Guide)

Children’s safety equipment and protective clothing – to protect against Ebola
 As with any viral outbreak that has the potential to mutate into an epidemic, it is essential to be prepared with the necessary protective safety wear that gives a level of defence against the virus.
As with any viral outbreak that has the potential to mutate into an epidemic, it is essential to be prepared with the necessary protective safety wear that gives a level of defence against the virus.
One of the most common mistakes you can make is to have insufficient amounts of protective clothing.
The next commonly overlooked area is children’s safety equipment and protective clothing.
This article is very specific to this important area of surviving and epidemic.
As with all adult protective clothing, all areas must be protected in order to stop the virus spreading – contact with body fluids is the number one level of defence in the case of the Ebola Disease Virus.
Children’s safety equipment and protective clothing : Top 3 Essential Safety Items
A child sized mouth and nose mask
Available from 3M and gives protection against fluid splashes and prevents ingestion by the child.
The N95 Health Care Respirators come in pack of two.
Child sized medical gloves:These small sized gloves for children are available in clear or blue latex and suitable for smaller hands. The Reliance Medical Religlove Nitrile Powder-free and the Clear Vinyl Gloves are both available by the box of 100. |
|
 |
 |
Eye protection:

Small child sized goggles.
The eyes are another essential area the should be protected from any splashes or unwanted body fluids.
These small liquid proof Children’s Safety Goggles (small) will prevent this from happening.
additional reading:
If you liked this article - Please Share It
]]>
Signs and Symptoms of Ebola
There is currently no vaccine or know cure for the Ebola Disease Virus.
Symptoms of Ebola include
- Fever (greater than 38.6°C or 101.5°F)
- Severe headache
- Muscle pain
- Weakness
- Diarrhea
- Vomiting
- Abdominal (stomach) pain
- Unexplained hemorrhage (bleeding or bruising)
Symptoms may appear anywhere from 2 to 21 days after exposure to the Ebola virus, but the average is 8 to 10 days.
Recovery from Ebola is possible and generally depends on that person being in good health, having good supportive clinical care and the patient’s own immune response.
People who have recovered from the Ebola virus infection develop antibodies that last for at least 10 years.
Scientists are now working rapidly to produce a safe vaccine for the virus.
.
related articles:
- Epidemic Protective Clothing and Equipment
- How to Prepare and Survive an Epidemic
- Children’s protective essentials
.
If you liked this article - Please Share It]]>
Epidemic Protective Clothing and Equipment
 Whenever there is any sort of viral outbreak or potential epidemic, you will always see rescue and medical personnel wearing protective clothing.
Whenever there is any sort of viral outbreak or potential epidemic, you will always see rescue and medical personnel wearing protective clothing.
Specific epidemic protective clothing and equipment is essential for both the medical teams and the victims themselves.
Most viruses can be very quickly identified and their severity categorized in order to establish the methods of virus transfer.
Once the virus has been identified, it will then dictate the level of protection required for the medical team workers. Although, with most outbreaks, the medical and civilians will fully ‘suit up’ in the early stages to ensure full body protection – this is just normal procedure.
If the virus is identified as being an airborne virus – one that can only be caught by breathing in through the mouth or nose, then the very minimum requirements are a good respiratory mask.
 With the current outbreaks of the Ebola Disease Virus it is known that the virus spreads through contact with an infected person and more specifically, through body fluids – this would include saliva, sweat, blood and vomit.
With the current outbreaks of the Ebola Disease Virus it is known that the virus spreads through contact with an infected person and more specifically, through body fluids – this would include saliva, sweat, blood and vomit.
Common symptoms of the Ebola Virus are, sudden temperature, muscle aches, vomiting or a rash, these might indicate you have the disease.
Of course the best way to avoid catching just about anything is to distance yourself from the area and anyone who may have the virus.
Having said that, there are specific procedures and processes laid down by the CDC ( Centre for Disease Control and Prevention ) which are the first line of defence to protect anyone who may be in a high risk area.
Again, using Ebola as the typical example:
If you travel to or are in an area affected by an Ebola outbreak, make sure to do the following:
- Practice careful hygiene. For example, wash your hands with soap and water or an alcohol-based hand sanitizer and avoid contact with blood and body fluids.
- Do not handle items that may have come in contact with an infected person’s blood or body fluids (such as clothes, bedding, needles, and medical equipment).
- Avoid funeral or burial rituals that require handling the body of someone who has died from Ebola.
- Avoid contact with bats and nonhuman primates or blood, fluids, and raw meat prepared from these animals.
- Avoid hospitals in West Africa where Ebola patients are being treated. The U.S. embassy or consulate is often able to provide advice on facilities.
- After you return, monitor your health for 21 days and seek medical care immediately if you develop and signs or symptoms of Ebola.
* taken directly from the CDC prevention literature information.
What is the correct Epidemic Protective Clothing and Equipment for people..?
 1) For the Ebola Disease Virus, the absolute, very minimum is a Standard Surgical Face Mask like the one shown here.
1) For the Ebola Disease Virus, the absolute, very minimum is a Standard Surgical Face Mask like the one shown here.
This will give you adequate protection against any infected body fluids and stop any the fluids from entering the nose and mouth – and this includes someone sneezing!
This type of mask is cheap to buy, disposable and will give you ample protection.
* Remember, you are not trying to filter the air – purely protecting your mouth and nose area.
There are other types of face mask available that will give the same protection as shown here:
Current Price: £11.99
Price Disclaimer
|
 Of course, as preppers you should already be carrying a couple good dust masks in your EDC bag.
Of course, as preppers you should already be carrying a couple good dust masks in your EDC bag.
– if not, and there is potential contact with an infected person, you would use a bandanna, hanky, scarf or anything else to stop ingestion through the nose and mouth.
2) Eye Protection – Fluids can also be ingested into your body via the eyes – sneezes, splashes, rubbing your eyes with infected hands – these are all means of entry into your body.
The eye protection must be fully enclosed, like the Baratec Eye Protection (Against Liquid And Dust) as shown here.
Mouth, Nose and Eye protection are your minimum requirements to prevent any infected fluids from getting in.
3) Disposable Gloves – if you are liable to be touching anything to do with an infected person, you must wear medical gloves – double gloving is also better. Medical grade gloves are preferred, like the MediGuard Nitrile Disposable Glove shown here.
4) Disposable Coveralls – should you have a cut or open wound, a graze or similar, and you are in contact with the virus, it can still ‘get in’ via these routes.
So your next level is to cover your body with a disposable coverall, using something like the Tyvek Disposable Coverall like these shown here.
Personal Hygiene Requirements.
It is very important to remember what you have actually touched with your bare hands. A virus can stay on your hands and as soon as you rub your eyes or put your hand near your mouth it can be transmitted into your body.
It is very important to sanitize your hands with a medical gel sanitizer.
The antiseptic gel must be hospital grade, alcohol based and used every time, before and after putting on any gloves.
The Purell Antibacterial Alcohol Hand Rub Gel Cleanser Sanitiser shown here is an ideal choice to carry with you.
.
.
Remember – all these measures are pretty common sense, as is ‘avoiding contact with an infected person’, if the virus is unknown, it is advisable to take maximum precautions where possible and fully equip yourself with as much protective wear as you can.
A good prepper will have several of these items already – but always ensure you have enough for yourself AND your family – always be prepared……
.
.
related articles:
- Signs and Symptoms of Ebola
- How to Prepare and Survive and Epidemic
- Children’s protective essentials
.
.
If you liked this article - Please Share It
]]>
What are the basic survival skills 
When SHTF and the choice of hunkering down or bugging out has to be made. If that choice is to bug out then it becomes a real survival situation, every prepper should know them, but what are the Basic Survival Skills for staying alive.
Without these skills your chances of survival are greatly reduced, leaving your survival to trial and error.
So what are the Basic Survival Skills you must have?
In order to understand the basic survival skills that a prepper must know it is even more important to know what the biggest threats are to your survival in the first place.
Understanding these threats are your biggest weapon to helping you survive and overcome them.
There are 3 main threats that will halt you in your tracks if your not prepared for them –
- Exposure
- Dehydration
- Starvation
And to combat these 3 threats there are 4 immediate responses to ensure survival –
- Shelter
- Water
- Fire
- Food
- Extreme weather can kill you in a matter of just 3 minutes -
- A lack of water can kill you in 3 days -
- No food will kill you in only 3 weeks -
Therefore the importance of knowing the top 5 basic survival skills are paramount to any prepper
1. Know how to build a shelter and set up a camp
2. Know how to start a fire using foraged materials
3. Know how to find water and filter it or to distill water from the sun
4. Know how to set snares, traps, fishing and hunting skills and gathering food from the land
5. Know how to butcher and prepare fish and game
Most preppers will already have a basic knowledge of these skills. In fact you don’t even need to venture outside to learn how to do them – just go on-line – but nothing beats the actual experience of doing and practising these top 5 basic survival skills, outside, in the wild.
 * A Survival Shelter can be something as simple as a few logs and twigs propped up against the branch of a tree, with a few branches and leaves thrown on top. A few more leaves on the floor and your good to go – It’s enough to keep the wind or rain or snow from settling on you.
* A Survival Shelter can be something as simple as a few logs and twigs propped up against the branch of a tree, with a few branches and leaves thrown on top. A few more leaves on the floor and your good to go – It’s enough to keep the wind or rain or snow from settling on you.
* Start a fire as soon as possible after the building your shelter – this is like Feng Shui for survival – many survival knives have built in fire starters that are excellent and work every time. Get yourself a good supply of wood stored under your shelter if possible and now you have a means to dry your clothes, cook and sterilise water.
* Collect your water – Ideally use a filter system or a filter straw that will give you an instant drink. Learn how to distil water from the sun using the various survival methods.
 *Set snares and traps and fishing lines and begin a campaign of hunting for your food –
*Set snares and traps and fishing lines and begin a campaign of hunting for your food –
Learn tracking methods how to set humane kill traps – ensure you have a means to get sufficient food and be able to start a store of food. This will also mean buying and using an air rifle or a hunting catapult and practising these skills until your confident
* Acquiring your dinner is one thing but you need to know how to skin and butcher your catch – you must learn skinning techniques and gutting as well as bush-craft skills on preserving your food. This will become essential in any long term survival situation –
Survival in the wild can be as easy or as difficult as you make it. Of course, once again, it all comes down to being prepared – and that’s what we’re all about – as a prepper learning these basic survival skills must be an essential part of your overall prepping plan – learning these skills is also fun and gives you a great sense of achievement and self worth, you can even practice some these in your garden!
By fully understanding ‘What Are The Basic Survival Skills’ any prepper will be ahead of the game should they ever be needed, your survival chances are increased, after all, that’s what we all strive for – Happy prepping folks
]]>
How to Prepare for and Survive an Epidemic
What is an epidemic?
An epidemic occurs when there are new cases of a certain disease among a given human population during a given period, and that disease substantially exceeds what is expected, based on recent experiences.
It is not to be confused with an “outbreak” which affects a smaller group in a very specific area.
Causes can be ‘source outbreaks’ where everyone was exposed to the same agent and then there is a ‘propagated outbreak’ where humans have become or are the source and the disease and then it can be transmitted from one human to another.
Typically, an epidemic will have both characteristics because once a human is infected from a common source they can then infect others that have not been exposed to the common source.
What Is an Epidemic and What Does It mean for You?
 Biological warfare has been around for hundreds if not thousands of years. In some military campaigns, military commanders would literally toss diseased corpses of victims into the camps, towns and even the cities of their enemies to spread the disease.
Biological warfare has been around for hundreds if not thousands of years. In some military campaigns, military commanders would literally toss diseased corpses of victims into the camps, towns and even the cities of their enemies to spread the disease.
Today however, technology allows for ‘multiple dispersal systems’. Essentially any contagious disease can be spread into a heavily populated area quite easily without anyone being aware until people begin showing symptoms.
Heavily populated areas are targets for biological attacks because of the increased human element. A small vial of any disease can be used to infect a large number of people quickly even if only a few are initially infected because of people’s ability to travel great distances in a short period.
Once one person is infected, the disease can spread throughout the city, country and eventually the world.
Unless there is information of an attack, the only way, you or anyone else will know is when the actual disease itself manifests itself in humans.
At this point, you will not know if the water or food supply is contaminated, if the disease was spread by aerosol canisters from aircraft or if it was a smashed vial at a train station.
If you suspect it was a deliberate biological attack, stop drinking your tap water and begin using your emergency supplies.
Various diseases are water-borne and it is possible the local water supply has been contaminated.
Do not bathe or prepare meals using your local water supply and begin using hand sanitizer and body wipes for personal hygiene.
Do not leave your home. Any fresh fruits, vegetables or any fresh foods should be discarded because you have no way of knowing if the food supply has been contaminated as well.
What Is an Epidemic and How Do You Survive One?
One of the best defences against any disease is a healthy body. Rarely does any infectious disease have a 100 percent mortality rate unless that disease has been mutated purposely and specifically for a so-called germ warfare program.
For example – Ebola, called the Ebola Virus Disease, has a mortality rate of roughly 68 percent.
However, there is currently no vaccine or treatment available for the Ebola virus and once infected there is 99.9% of certain death.
The Ebola virus will incubate within the body for several days before showing signs of infection – this is where it is at it’s most dangerous as it can then be unknowingly spread to others.
If there is an infection in humans, the Ebola virus can be spread in several ways.
Ebola is spread through direct contact (through broken skin or mucous membranes in, for example, the eyes, nose, or mouth) with
- blood or body fluids (including but not limited to urine, saliva, sweat, feces, vomit, breast milk, and semen) of a person who is sick with Ebola
- objects (like needles and syringes) that have been contaminated with the virus
- infected animals
- Ebola is not spread through the air or by water, or, in general by food.
- However, in Africa, Ebola may be spread as a result of handling bushmeat (wild animals hunted for food) and contact with infected bats.
- There is no evidence that mosquito’s or other insects can transmit Ebola virus. Only mammals (for example, humans, bats, monkeys, and apes) have shown the ability to become infected with and spread the Ebola virus.
Protections against any disease include good sanitation practices, avoiding persons/areas infected and using personal protection equipment when around anyone infected.
Clean drinking water, good health and nutrition and an overall clean living environment is what is needed to survive an epidemic.
Once there is evidence of a disease spreading quickly, quarantines may be put into place and this is problematic if you have not prepared.
You will be unable to Bug Out as the authorities may restrict travel to prevent the spread and this may mean you are forced to live in an area where the disease is present.
**This means you may not be able to leave to gather any supplies or materials you may need.
What Is an Epidemic and How to Prepare For One ?
?
The main areas where you can protect against any virus are through reducing the amount of direct contact with an infected person, proper sterilisation of any equipment handled by yourself and stopping any airborne particles from entering your body from an infected person.
With an airborne virus, the minimum protection is a face mask filter – A Moldex FFP3-D Reusable Mask shown here, is specifically designed to protect against airborne diseases that are spread by humans and various other dispersal means that would cause the disease to become airborne.
Although many viruses are not airborne, a mask will protect your mouth, preventing accidental ingestion of any fluid or such like.
This is an important 1st line of defence against ANY potential epidemic.
Additional personal protection methods would include Tyvek Disposable Coverall , Nitrile Powder-Free Gloves , Eye protection and Disposable Shoe Covering that protect against bodily fluids such as blood and saliva.

It is important that you have enough safety protection equipment for each person in the family and those with a disease should wear a mask as well as those not infected.
Hand and body cleansing is important so a fresh and adequate supply of clean water is needed as well as hand sanitizer and soaps.
Hydration needs will increase for those infected so extra water supplies will be needed.
Stay informed of all events happening in the area and world by monitoring local and world news organisations. If your neighbour has to knock on your door to inform you of a problem in the area, and by the way, they might be infected, then your chances of survival have decreased dramatically.
Other Emergency Essentials to Have On Hand
- Hand Sanitizer that contains at least 60 percent alcohol, soap and pre-moistened bathing wipes
- Duct tape and sheets of plastic for covering windows and slowing down the spread within the home/area by quarantining certain areas using Heavy Duty Polythene Sheeting.
- One Month Water Supply and if preparing for an epidemic use the recommended amount of 16 litres per person daily to calculate total amounts needed. An average healthy person needs at least two litres daily to maintain hydration levels, people infected may require twice these amounts or even more daily for hydration and personal hygiene.
- Additional water safeguards would be good quality Water filtration bottle suitable of delivering enough safe water for your family.
- A minimum of one months supply of tinned foods and other Self Heating Field Ration Pack Ready To Eat Meal that do not require any preparations
What Is an Epidemic and Should You Be Worried About One?
You should be concerned, but not to the point of panic and to where it disrupts your daily life.
To survive you must have information and know how to implement protective measures – Staying in place once there is an epidemic can reduce your chances of infection unless you are close to a biological attack.
If this is the case, you must grab your bug out bag and go – by being prepared to do this immediately will increases your chances of survival.
You must be clear of the area before quarantines are put in place because local officials may very well block you from leaving.
On the other hand, you do not want to flee if you are infected because you may not have access to medical care if you leave the area and you will spread the infection to others.
Being informed is crucial, you must have information to make the decision on whether to evacuate or stay.
What is an epidemic and will you survive one?
Yes, you can survive if you have prepared and know where the so-called common exposure risk is highest and you must always assume any person can spread the disease.
In other words if there is an attack or an outbreak in a certain area that is likely to develop into an epidemic then you should have enough information to decide if you should leave immediately or take precautions and stay in place.
If there were a biological or terrorist attack, where an epidemic outbreak resulted from a chemical attack, you would have limited time to prepare for yourself and your family – unless you have been able to systematically gather extra provisions over the last weeks and months, you have just left yourself wide open to being at high risk.
Related articles:
- Epidemic Protective Clothing and Equipment
- Signs and Symptoms of Ebola
- Children’s protective essentials
Of course, this is the essence of prepping.
Having the provisions and learning the skills to survive BEFORE you need them.
If you liked this article - Please Share It
]]>
Surviving Winter if you are stranded in your car 
Being stranded in your car in nice weather is bad enough, but getting stranded in ice and snow and surviving winter weather is something you must be prepared for.
As preppers we all prepare for natural disasters of one sort or the other.
The UK Winter is something that we also need to prepare for as well.
The basic risks still exist – and during the winter months the risk of hypothermia is higher than at any time.
In order to survive the winter weather, it is essential to be fully prepared and have the correct equipment with you,if you were to get yourself stranded in your car – breaking down in the snow and ice or just sliding of the road and getting stuck can be quite dangerous at the least and potentially fatal in the worse can scenario.
Being fully prepared with the correct winter survival kit is essential to keep yourself alive until help arrives.
The basic 5 rules of survival still apply to surviving winter in your car – but remember, always adapt the amount of survival preparation to suit your own families needs and consider a worse case scenario of a car full of adults – you must have enough survival equipment and supplies for this.
Below is a comprehensive Vehicle Winter Survival list of equipment with direct links to the manufacturers reviews, information and prices:
Shelter:
* this is your number 1 concern and your most important survival choice
- Your car will provide the shelter from the elements – do not leave your vehicle unless you are fully equipped to do so and you know exactly where you’re going and how to get there and how long to get there.
- TIP: write “HELP & SOS on outside of windscreen and back window
Warmth:
* being able to keep warm and offset hypothermia is essential to survival
- Emergency clothing – Thermal Insulated Gloves / Thermal Socks / Thermal Winter Hat
- Survival sleeping bag

- Foil Survival Emergency Blanket
- Emergency Instant Hand Warmers
- Emergency Instant Foot Warmers
- 30hour Survival Candle
- TIP: Run your car engine for short amounts of time [5-10 mins] to stop freezing and run heater [set to feet only, as heat will rise] to add warmth inside. Ensure nothing is blocked that will allow fumes into the cabin area [eg: the exhaust] and keep all windows closed to prevent fumes entering.
Water & Food
*have a supply off water & food for at least 48 hours
- Bottled water – minimum of 1x5ltr plastic bottle per person

- Flavoured drinks – maybe a few energy drinks
- Personal pure water filter
- Self Heating MRE ration packs
- Snacks: Energy chocolate bars
- TIP: Remember you will need something to drink out of and also to melt snow in and a knife, fork and spoon.
Lighting, Communication
*modern survival equipment can will make getting stranded in your car very much easier to survive
- LED Torch and SOS signalling, with Batteries
- Torch/Lantern Wind Up with SOS signalling, no batteries required
- Emergency Light Sticks [12 Hour Glow Sticks]
- Mobile phone
- 12V phone charger lead and socket
- TIP: use the emergency glow stick to provide a light inside your car at all times to show rescuers you are there. Also you can tie a glow stick onto some string or use a shoelace – if you swing the glow stick around like your lassoing something it makes a far more visible distress signal that can be seen at night and by air.
Other essential winter survival items
*these items will help out in any emergency situation
- Gorilla Tape 32m
- Multi-Tool
- AA Ultimate First Aid Kit
- Personal medication [if you take medicine daily carry pack amounts]
- 550 Paracord Neon Orange
- Emergency Multifunction Rescue Tool
- Emergency [must be loud] Whistle with Lanyard
- Toilet paper
- Change of clothes
- Emergency Snow Shovel
- Heavy Duty Jump Leads
- WD40 Aerosol
- Spare pair of Boots or Wellingtons
- Antiseptic Hand & Surface Wipes
- TIP: avoid wearing cotton clothing as this has been proved to reduce body temperature.
Other additional winter survival equipment worth considering if you have the space
*not essential, but might make life a bit easier and help pass the time..!
- Compact / portable Gas Stove
- Cooking set – cup, pan etc
- Soup
- Tea, coffee, hot chocolate
- Deck of playing cards
- Hand held games machine
- Disposable toothbrush set
- A few magazines or a book
 All the items above may seem like a lot, but you can get them all packed into one box and keep it in the boot of your car quite easily. Of course the very best way to surviving winter if your stranded in your car is, “Don’t go out in your car in the first place”..!
All the items above may seem like a lot, but you can get them all packed into one box and keep it in the boot of your car quite easily. Of course the very best way to surviving winter if your stranded in your car is, “Don’t go out in your car in the first place”..!
But sometimes winter journeys are necessary and you will always risk skidding off the road or just getting caught up in a motorway snarl up where no one can move.
If this ever happens to you and your not prepared then it’s only ever one persons fault – your own..!!!
Get yourself prepared for winter:
Being prepared and surviving the winter weather if you ever did get stranded in your car is easy if you have an emergency kit and a plan – but, as usual, it all comes down to ‘getting your act together’ and doing it now before your in that emergency situation – in fact I think it’s essential to carry an emergency survival kit at all times in your car.
Happy prepping folks……
If you liked this article - Please Share It
]]>
What would you do in a total UK Blackout 
Electricity is taken for granted by just about everyone [except, maybe us preppers!] But, have you ever stopped to think what would happen if there was a total blackout of the power grid in the UK?
This scenario is probably one of the most possible UK meltdown disasters that could hit us here in the UK today.
What would cause a total UK Blackout.
- There are a few reasons the National Grid might fail – some on a temporary basis and others that could cause a catastrophic effect and easily set us back years – possibly hundreds of years as we are just not used to having no power – our ancestors coped because they had been born into times when electricity was never there and they learned the skills and lifestyle to be power free ,
21st century living has made us dependent and very vulnerable.
With the National Power Grid disabled we would be up the proverbial river without a paddle, in fact I think we would be up the river without a boat as well..! We are simply just not prepared for this disaster scenario.
Unless, of course, you are one of the completely mad bunch of loonies know as UK Preppers. If you are, you would of already thought through this situation and made your plans, stocked up and be fully prepared to survive.
Have learnt survival techniques and skills that will ensure you are self reliant and be able and confident you can both protect and look after yourself and your family.
No mean feat, but that’s what prepping is all about…
So what are the likely causes of a total UK Blackout.
- Terrorist attack – physical, eg – blowing up power lines, power generating sources etc

- Cyber attacks – infiltrating the power systems computer systems to initiate meltdown
- War – nuclear attack
- Natural disasters – earthquake, flooding etc
- EMP – Electromagnetic Pulse –
All of the above are possible, but, in many experts eyes, unlikely.
Some are predictable and therefor precautions can be put in place to combat the threat.
EMP’s and the threat they offer would be a world wide disaster, but these too are monitored very closely. Although it is universally accepted that an EMP will happen one day – but when is just a wild guess.
Short or long term Total UK Blackout.

A long term blackout in the UK would cripple our whole infrastructure and lifestyle. Bringing everything we took for granted to a complete standstill from the moment you woke up to the last thing at night.
Within days the whole country would be in full on panic mode with nothing left on the shelves at any stores. Fuel supplies would dry up almost instantly, communication systems would fail and unless you are battery or solar powered the nights would be very dark indeed.
Imagine if this were to happen in winter. How would you keep warm?
- I guess your getting the bigger picture now..!
We can cope with a short term blackout in the UK, in fact in many parts of the country they still happen.!
But even so could you manage for a week?
Think about it – no cooking, no heating, no nice hot water, can’t get to work because the petrol station can deliver petrol, can’t get a train because they are all disabled with no power…… the list goes on and on and that’s just for a week.!
Do a test run – I dare you !
Try it, just for a day or two, test yourself, see what it actually means to have no electricity for two days – just see how it makes you  rethink your whole methods of living. You will be very surprised at the outcome I can assure you.
rethink your whole methods of living. You will be very surprised at the outcome I can assure you.
Then, once you have tried to live for just two days without power, assess what you needed and put those things in place.
Then go for another test of a whole week – and see if it’s a bit easier now being more prepared. You will still be surprised and rethink and regroup your survival methods for a total blackout.
This is a great way to be ready for this type of disaster scenario.
So what’s the answer
 By now I think it’s quite clear what is needed if this were to happen – just do a little prepping first - Be Prepared.
By now I think it’s quite clear what is needed if this were to happen – just do a little prepping first - Be Prepared.
It’s not a mad idea to get some extra supplies in, maybe some extra batteries and simple survival provisions learn more about survival skills and learn how to be that bit more self sufficient.
It doesn’t have to take over your whole life – but with a little bit of time spent prepping it could actually save your life.!!!
Without doubt, the minimum requirements for a blackout must be torches. But, forget the batteries and your back to  square one – even if you had dozens of packets of batteries they would run out very quickly.
square one – even if you had dozens of packets of batteries they would run out very quickly.
The answer is to invest in either solar powered torches [at least that way they will be able to be charged during the daytime] or go for the wind up type. These have come a very long way in the last few years and are a more sensible investment for when the sun goes down.. A lot of wind up torches are also capable of charging a mobile phone or laptop as well.
Next on the list is the old favourite, candles. On the one hand they also offer a source of heat, but again they will run out eventually.
Are there Government plans in place?
Well, yes there are some quite specific plans already laid out and passed by government to cover these sort of disaster scenarios. You can view them here:
PDF: National Risk Register of Civil Emergencies
There’s also a Response & Recovery plan in place, this can be viewed on the governments own website:
emergency-response-and-recovery
What can you do to make your blackout life easier?
- Ensure you have a good knowledge of the 5 basic prepping skills of survival
- Always have a good EDC with you
- Avoid making any of the basic prepping mistakes
- Ensure you have the essential equipment for home survival *see below
- Think well ahead, make a plan and begin a campaign of sensible step by step prepping
Essential home survival equipment

- Drinking water & Food supplies. see more
- Personal medical supplies. see more
- Communication equipment
- Equipment for lighting. see more
- Method of heating
- Cooking facilities. see more
- Sanitation
- Safety. see more
Where do you fit within the Preppers Pyramid – Do you have any of the basic essential home survival supplies and equipment
Finally:
Prepping for most situations can be easy – this UK Preppers Guide website is full of information, help, tips and advice on what to buy and where, but it’s up to you to make it happen.
A total blackout would cause chaos and the breakdown of our society as we know it – do you want to be part of that.?
If you liked this article - Please Share It
]]>
How to prepare and survive an electromagnetic pulse 
An Electromagnetic Pulse (EMP) is, simply stated, a burst of electromagnetic energy. It can occur as a radiated, electric or magnetic pulse.
An EMP is usually damaging to most electronic equipment including household appliances, automobiles, power grids and communication systems.
Certain equipment can be shielded from the damaging effects of the pulse however.
Naturally occurring EMP’s can be caused by lightning and from electrostatic discharges when two charged objects come in close proximity or by making contact.
An EMP can also be caused by a surface or atmospheric nuclear detonation. To create an EMP over a large area an atmospheric nuclear detonation would be the logical choice. A rocket would be launched into space and the nuclear warhead would be detonated at a certain distance above the earth’s surface.
An EMP can be manmade, as well, and equipment designed to produce an Electromagnetic Pulse is generally used to target specific buildings, installations and equipment.
A Note about Solar Storms
A major solar storm is inevitable according to most experts. A solar storm will cause an electromagnetic disturbance and  one large enough could cause widespread destruction of any country’s power grid. However, while a solar storm of a large enough magnitude could very well destroy a large portion if not all of the world’s power grids it poses little threat to electronic gadgets, and will not disable automobiles, planes or trains.
one large enough could cause widespread destruction of any country’s power grid. However, while a solar storm of a large enough magnitude could very well destroy a large portion if not all of the world’s power grids it poses little threat to electronic gadgets, and will not disable automobiles, planes or trains.
Power companies do have the technology to protect power grids against a solar disturbance. However, whether they have or will do so at some point remains to be seen. Once damaged by a solar disturbance the worlds or any nation’s power grids would take years to repair if they could be repaired at all.
How an EMP Affects You
Today an EMP is much more likely than say 50 years ago when nuclear technology was in its infancy stages. Today a few pounds of enriched plutonium launched into space on a satellite in place of its cameras would cause widespread devastation worldwide. The effects would be greater as well because today everyone has an ever-increasing dependency on electricity. Some rely wholly on it for the basic maintenance of their lives.
There is a belief that a long-term loss of electricity would put the world or a country back 150 years. However, keep in mind there was not any infrastructure to speak up 150 years ago, so people knew how to survive without electricity. Therefore, a long-term outage would put us back half of a millennium or more because of our lack of knowledge on how to survive without electricity.
No one today truly knows whether the world or a country can survive without electricity because no one alive today has ever had too.
There will be casualties caused by the effects of a pulse. A widespread loss of electricity will cause mayhem in any community. Hospitals and care centres will not be operational because backup generators will not operate, lifesaving equipment would soon be so much clutter under foot. Emergency services will be shut down as well, which means no law enforcement or emergency response to medical emergencies.
 Battery operated torches and radios will cease to work if they have an electronic circuit board in them. Most automobiles manufactured after 1960 will not operate unless the vehicle was shielded.
Battery operated torches and radios will cease to work if they have an electronic circuit board in them. Most automobiles manufactured after 1960 will not operate unless the vehicle was shielded.
Aircraft can fail in flight because any navigational aids would be destroyed seconds after an EMP. Smaller aircraft can be flown without instruments, but many commercial jets and other aircraft rely on electronics to navigate. Only those that can fly by dead reckoning without instruments would have a chance of landing safely.
Literally, an Electromagnetic Pulse could mean aircraft would be falling from the skies causing untold numbers of fatalities.
People not prepared could very well succumb to hypothermia and hyperthermia. Dehydration will be a threat for many in a matter of days as well as starvation in the days after. Mobile and landline phones will not function and any hand-held communications devices unless properly shielded will not operate after an EMP.
What Can You Do
Prepare to live without electricity, which means you as an individual or family are on your own in the first few weeks, months or possibly years. You must be self-sufficient enough to survive until the damage can be repaired. You have to remember that any task you complete today using electricity will still have to be completed in the days after the power goes out.
Faraday Cage
A Faraday cage is simply a way of protecting electronic equipment from an EMP. It can be as simple as wrapping a device in aluminium foil. The cage must be made of a conductor of electricity ideally copper, aluminium or steel. The items protected should be nested inside the cage with Styrofoam or other plastic material without touching the metal walls. Ground the metal cage if possible.
If using foil, wrap the devices and then place in a plastic bag/other plastic material and then wrap again in foil. The more layers of foil and plastic you have the greater protection afforded. This is a very rudimentary shielding method but can be used when no other materials are available.
An anodized aluminium rubbish barrel can be made into a shielding device by grounding it or even burying it so the lid is at least a half of a meter under the soil. Place items in the barrel so they do not make contact with the sides. You can use Styrofoam pieces or bubble wrap to nest the items in the cage.
A microwave oven can be used as a Faraday cage. Place your items in the oven and place the oven near a metal water pipe and solder or otherwise connect a piece of copper wire from the microwave over to the water pipe to create a ground. The pulse will flow over and around the oven and seek the ground. Most plumbing systems are grounded if you have metal piping, sometimes referred to as “electric earthed” to the water supply. You can however use a Faraday cage without grounding it.
An Electromagnetic pulse will destroy computers, USB devices, hard drives and any device that has an electronic component in it. You will have to choose what devices to shield keeping in mind even though your device may have been spared it may not work because the power grid is not operational. Most devices rely on a power grid and a functioning infrastructure to operate.
Communications
Two-radios and ham radios are necessary so you and family members can keep in contact and possibly monitor for public information. Torches, mobile phones and other battery-operated devices along with the batteries should be shielded as well.
It is likely that most if not all mobile services will be disrupted but you simply do not know how long, so make sure you have the means to communicate if the damage to some systems can be repaired. Older model or shielded generators may come on line so there may be some limited services.
Vehicles
For most people it would not be practical to try to shield a full sized vehicle but a small motor bike/scooter could be shielded. The roadways will be clogged with stalled automobiles, so it is unlikely you could drive any significant distance even if your vehicle was operational. Bicycles can be used as well as small motorbikes such as a Vespas motor scooter to navigate around obstacles on the roadways.
Essentials
You always have to assume the worst otherwise you would never be prepared. You should have at least a 90-day supply of food, water, medicines and medical supplies. Once people realize there was an EMP, panic will ensue and the shops and other establishments will be looted quickly. You will not be able to go shopping to get anything at this point.
The pulse itself is not dangerous to you physically but the results of the pulse will be. The thing you need to fear the most in some cases will be other humans once desperation sets in. Keep the fact you are a prepper and therefor are well supplied a secret from everyone.
You need protection from the cold so have plenty of blankets/thermal blankets and wood or coal if you have a fireplace/stove. Most people rely on the village main for their water supply so you may not have running water. Private water wells are one option if you have the means and property to have one dug or drilled and remember you will need to have hand water pumps installed.
Charcoal or bottled gas is an option for cooking and gas can be used for heating in some cases but you will not be able to resupply. Of course, you can only cook using charcoal or wood outside.
Laundry and bathing will be a problem because of a limited water supply and not having the ability to heat water efficiently. Hand wash clothes and bathe using collected rainwater. You can place water collection barrels to capture runoff but ensure the barrels are screened to filter out debris and prevent insect breeding. Use large kettles to heat the collected water for laundry and bathing. It is impractical to think you can store enough water in jugs to sustain you indefinably so you will have to develop alternative means of obtaining water.
| Essential EMP preparedness and survival books | ||
| Solar Flare Preparation/Survival | EMP Disaster Survival | Disaster Preparedness for EMP |
 |
 |
 |
An Electromagnetic Pulse will disrupt your life and the lives of everyone around you for weeks, months and possibly years. Begin now imagining how you will perform your daily tasks without the benefit of electricity and all of the modern day conveniences that make life easier. It will take planning so begin now learning what you need to do to survive without electricity.
If you liked this article - Please Share It
]]>
How to Survive the Cold Weather At Home, If You Are Stranded or Have to Bug Out 
Hypothermia is a medical condition diagnosed when your core body temperature drops below what is required for normal functions and metabolism. Typically, a drop of three degrees in your core temperature means you have hypothermia.
On average, normal body temperatures are between 36.5 and 37.5ᵒC (98-100ᵒF). You do not have to be exposed to extreme cold for hypothermia to be a threat.
If you are exposed to temperatures around 10ᵒC, (50ᵒF), and have on wet clothing or are submerged in water then hypothermia is a serious threat.
Being exposed to what you would consider cool temperatures for prolonged periods without protection can bring on hypothermia as well. Older adults and younger children can develop hypothermia from being in an air-conditioned room as can anyone else, if they have underlying medical conditions.
Protecting Yourself from Extreme Cold
 Power outages during the winter months can be deadly for people if they do not protect themselves. Your clothing is the first line of defence against the cold. Clothing should be layered with material such as wool or fleece next to the skin. Cotton is not a material you want next to your skin because it will hold body moisture (sweat) next to the skin.
Power outages during the winter months can be deadly for people if they do not protect themselves. Your clothing is the first line of defence against the cold. Clothing should be layered with material such as wool or fleece next to the skin. Cotton is not a material you want next to your skin because it will hold body moisture (sweat) next to the skin.
The process of evaporation of sweat is what cools the body and you will sweat in cold weather. You want material that wicks the moisture away from the skin to reduce the evaporative process. The next layer can be the last layer if it is insulated and waterproof otherwise you will need an additional outer layer that is wind and waterproof.
Layering of clothing allows you to regulate your body temperature to reduce sweating. If you feel warm, you can remove a layer to cool down slightly. Once cooled put the layer back on to prevent chilling. You must do what you can to prevent heavy sweating and thus body cooling in cold temperatures. It will only take minutes in some cases to develop signs of hypothermia.
The neck, head, armpits and groin area must be covered at all times when exposed to the cold.
Large arteries in these areas carry blood to and from the organs and warm blood flows from your inner core to the surface to warm the extremities and if these areas are exposed the blood will cool faster than the body can warm up.

Warm air always conducts to extreme cold air so if your head is exposed the warm body heat will conduct away from the body. It is important that you have protection that reflects body heat back to the body and not away from the body.
Thermal (Mylar) blankets are ideal for protection from the cold because they are designed in some cases to reflect over 90 percent of body heat back to the body.
A Mylar blanket is a perfect prepper item to carry in your EDC or bug out bag for an emergency situation and the good thing is they are very cheap at under £20 for 4 full size blankets. To see more information, click here.
Inside Your Home
If you are inside your home without heat, you should gather everyone in one room in the centre of the home. Plan to have them sleep there if it is possible. If there are, windows or doors that do lead outside you should cover them from the inside with thermal blankets or other material to keep heat from conducting to the extreme cold outside. The warmer it is inside the home the faster heat will conduct to the outside, so at some point, the conduction of heat will lessen and the air temperature in the home will stabilise.
Insulation between you and the floor is important when you are sleeping, if you are on a slab body heat will conduct into the cooler surface and if you have subfloors, heat will conduct through the floor into the cooler space under the home. An emergency sleeping mat is ideal for this, giving both thermal and reflective insulation between your body and the floor. I highly recommend the Highlander Aluminium Foil Camping Sleeping Mat as it is versatile enough to use both at home and in a emergency bug out situation.
Remove as much clothing as possible when sleeping if you have adequate blankets or sleeping bags. Clothing to include socks will become damp from perspiration and can cause body cooling if left next to the skin when sleeping. It is particularly important that you do not sleep with wet/damp socks on.
The digestive process will raise the body’s core temperature, so have everyone eat before sleeping to help warm the body overnight when it is the coldest.
If You Become Stranded In Your Vehicle
 If in your vehicle, cover yourself to prevent heat conduction and do not leave your vehicle unless it is unsafe to stay with the vehicle. Your car is your main shelter and you should never abandon it unless you know that help is close, wait for rescue.
If in your vehicle, cover yourself to prevent heat conduction and do not leave your vehicle unless it is unsafe to stay with the vehicle. Your car is your main shelter and you should never abandon it unless you know that help is close, wait for rescue.
Heavy snows are often accompanied by gale force winds, which will cause whiteout conditions and you can become lost just meters from your vehicle. Run the engine for ten minutes at a time every hour to warm the interior and the engine. Ensure the tailpipe is not blocked, which may cause dangerous fumes to enter the interior of the automobile.
If Stranded Outdoors
If there is not a shelter immediately available, you must get out of the extreme cold and begin working on a makeshift shelter. Getting under pine trees with heavy evergreen boughs can break the wind and it makes it easier to construct a shelter out of ponchos, tarps, branches or thermal blankets.
If there is deep snow on the ground, you can excavate the snow and create four walls of snow to break the wind. Dig down to bare ground if possible. If you have, tarps or ponchos use them for overhead cover. Leave enough space in the cover for smoke to escape if you have the means to build a fire. Ensure you have ground insulation such as pine needles, other vegetation or thermal blankets.
Do not lean your body against the walls of snow to prevent heat loss. The snow cave or shelter must be large enough for you to lie down without touching the sides. Properly constructed snow shelters can be as much as 15 degrees warmer than the outside air.
Ideally, as a prepper it’s worth considering carrying a storm shelter if venturing out in possible snow and blizzard conditions. There are some very good emergency storm shelters available. Lightweight and compact enough to fit in rucksack – my favourite is the Vango Storm Shelter 400 , an ideal bit of emergency kit.
Bugging Out
You may be put in a situation where you have to evacuate on foot and carry your emergency essentials with you. Bugging-out typically means you are leaving a dangerous situation for one less dangerous. Bugging out in cold temperatures has its own unique set of challenges.
- Exertion will cause sweating, which in turn cools the body. Layering of clothing is very important if you are hiking. You will have to take periodic breaks to allow your body to cool. Having dry socks available at all times is crucial and you should always have an adequate supply with you.
- You can develop trench foot or sometimes referred to as emersion foot from having wet feet for prolonged periods, and especially when exposed to cold temperatures. However, it does not have to be below freezing for you to develop trench foot. Wet feet will also mean a colder body. Dry your socks over a fire if possible and if not over a fire, open air dry and warm in a coat pocket before putting back on.
- Your bug-out-bag should have shelter materials and it is assumed you would have any cold weather gear on. It is important that you have adequate clothing so you can change out of damp clothes into dry warm ones. Always dry any article of clothing thoroughly before putting back into your pack.
- Ensure your pack is protected from moisture such as rain or snow by having a poncho large enough to cover you and your pack. A wet pack on your pack will cause your body heat to conduct to the cold wet pack.
- When taking a break check your feet, fingers, ears and cheeks for frost bite. The skin may feel number and slightly lighter in colour to the point of whiteness, which means blistering is not far off. Blisters filled with clear fluids indicate mild frostbite and blood or cloudy liquid indicates severe frostbite.
* To treat mild frostbite warm the body part immediately by gently blowing on it, placing under your armpits or cupping with your hands if it is an ear lobe. Cover or otherwise protect the area once warmed to prevent irritation from friction.
* Treatment for severe frostbite is best done by a medical professional to prevent tissue damage. If you realize medical help is not available warm the affected area slowly and cover once warmed. There will be pain associated with severe frostbite as the affected part warms.
Extreme Cold is Dangerous and regardless of how long you expect to be exposed, you should be properly dressed for the cold. Hypothermia if left untreated is fatal and severe frostbite left untreated will result in the loss of limb and/or tissue, and can lead to gangrene which is fatal if left untreated.
If you liked this article - Please Share It
]]>
How to Prepare For Flooding and Survival Techniques 
Through the autumn and winter of 2012, UK flooding has been some of the worst seen in decades. It has disrupted travel, destroyed homes and businesses and has cost lives.
Flooding is one of the more destructive natural disasters in terms of property damage and loss of life. Torrential rains and melting snows can cause rivers to over flow their banks, levees to burst and can cause flash flooding in areas that are not even experiencing storms.
Floodwaters can destroy infrastructure, cause power outages and literally trap people in their homes for days or even longer.
You can expect disruptions in public transportation such as rail and bus service and traffic jams during a flood. Even if your area has never experienced flooding in the past you are susceptible to flooding at any time during heavy rains or because of significant melting snows.
To check the current status of floods in your area and to check on warnings and alerts on UK flooding in general please visit the Environmental Flood Agency live flood warning website.
Preparations:
 Information is crucial because the more advanced warning you have the better you can prepare to protect yourself, family and possessions.
Information is crucial because the more advanced warning you have the better you can prepare to protect yourself, family and possessions.
Stay tuned to radio or television for updates.
Once you realize flooding is probable, begin moving possessions to upper floors or place them on high shelves. Evacuation is very likely during a flood and you want to be clear of the area before you are trapped by the floodwaters. You can however still prepare your home to lessen damage your possessions.
Food and water are the number one priority during any situation and ideally, you will have an emergency food and water kit, and if not begin filling jugs or any vessel that is safe for water.
For emergency purposes, the average person will need between two and three litres of water daily just to sustain proper levels of hydration.
Tinned food is recommended as an emergency food source because unopened tins are not susceptible to water damage. Each person will need one tin of protein, one of fruit and one of vegetables daily.
For real emergency food that is high in calories and will help you to sustain energy levels I suggest stocking up on MRE’s – Meals Ready To Eat [Self Heating Field Ration Packs] – these are designed for emergency situations and will give you much needed energy and nutrition.
Additional Emergency Items to be Prepared for UK Flooding
Food and water has been discussed previously
- Have an ample supply of torches and batteries

- Portable radio for monitoring information
- Emergency blankets
- Extra clothing
- Waterproof containers for cell phones and other small items
- Supplies for cleanup such as brooms and shovels along with large garbage bags/barrels
- Hand sanitizer
- Medical supplies
- Consider a portable battery system for charging electronic devices such as cell phones
- Medications and any medical devices needed such as portable oxygen tanks, crutches, canes or walkers
- Radio Frequency Distress or Personal Location Beacons are now legal in the UK for land use as of January 2012 so this can be an optional item and can be a critical item if you become stranded in your home or along the highway
 Move all supplies to upper floors along with all essential paperwork. Move blankets, clothing and personal hygiene items as well. Furniture can be placed on blocks or bags of sand to raise them up above any possible floodwaters that enter the home. Smaller furniture can be placed in large plastic bags and sealed.
Move all supplies to upper floors along with all essential paperwork. Move blankets, clothing and personal hygiene items as well. Furniture can be placed on blocks or bags of sand to raise them up above any possible floodwaters that enter the home. Smaller furniture can be placed in large plastic bags and sealed.
Keep in mind UK flooding in any area of the city will have an effect on you regardless of whether the waters reach your flat or building. Power will still be disrupted and streets can be flooded causing traffic problems and interruptions in rail and bus lines.
Once you know that floodwater’s waters will reach your home switch off the main gas and electric at the mains and turn off the water source.
Flooding will cause waters to be contaminated with raw sewage and various chemicals and toxins so you must avoid wading through the waters. Thoroughly wash your hands or use hand sanitize if your hands are submerged to prevent the spread of harmful bacteria.
Under no circumstances should you ever consume any floodwater’s or allow children to play in the waters.

If you have no access to stored drinking water then prepare by purchasing a good quality Water filtering bottle ( see review portable water filters). One of these Lifesaver water filter bottles will, purify any contaminated water and give you and your family safe drinking water (4000 ltr per bottle).
Avoid walking or driving through flooded streets because you can be swept off your feet by only 15 centimetres of moving water and less than a metre of moving water can sweep a vehicle away.
Manhole covers can be displaced by the waters so it is extremely dangerous to be out walking in any type of flooding. Downed power lines, trees and leaking gas lines are hazards as well.
If you encounter flooding, turn your vehicle around if safe to do so and find higher ground. If your vehicle stalls then move away on foot because you want to avoid becoming trapped in a vehicle being swept away. Even though the water is not yet deep, it may be soon so it is important that you move away quickly.
Bridges can be underwater to the point you do not recognize it as a bridge, may not realize there is a stream or river there, and so may assume it is only a few inches of water on a road
If you must evacuate, carry your kit that has your emergency food and water along with personal papers, medication, torches and clothing and any other items you need for the next few days. Being fully prepared with an emergency flood kit is essential to survive the first few days. A kit like the Emergency Go Bag 72 Hour Survival Kit is ideal for a flood situation.
It is important that supplies be packed in such a way that they can be carried with you. Do not assume that emergency centres will have any essentials available.
UK flooding will undermine the foundations on flats and other structures so it is important that you monitor the situation closely and if they recommend you evacuate your building you should do so. The waters will wash away the soil and weaken the foundations of buildings to the point the building can collapse.

Ensure someone knows your intentions whether you are staying in place or evacuating so, someone will know to alert rescue personnel and can give them a general or specific location to begin searching for you.
Flooding will cause many people to panic but if you are prepared with a flood kit and know what to do next, you can reduce stress and prevent panic in yourself and family members.
Being prepared before the crisis strikes will save lives.
You cannot properly prepare as floodwater’s are lapping at the front door. Being prepared is a state that should be maintained at all times because you simply do not know when the next disaster may strike.
UK flooding is a serious matter and the greater population density that we find in many areas will create more devastation because quite simply, there is more to destroy because of new construction of homes and businesses.
Flood protection products
The good old sand bag is still a tried and tested method of holding back the flood waters as they start to rise around you your house. But there are also a few other products that will also help prevent the water from seeping into your home.
Doorways and opening are obvious places where the water will penetrate – so block them off. The door opening can be sealed against water by using an instant door guard kit – designed to block off the main doorways and prevent water from getting past.
Air-bricks are also an often forgotten area where the water will enter your home. To reduce this risk fit an Air Brick Flood Seal, they only take a few minutes to fit an there in place, stopping the water.
You don’t necessarily need piles of sandbags, just the bag itself – again, be prepared, have a stash of Polypropylene Rotproof Sandbags ready and waiting to be filled.
Final thoughts…..
- Check out the possibilities of the area you live in becoming flooded.
- Check your household insurance – are you actually covered and insured for a natural disaster like a flood.
- Are you prepared enough for even a ‘small’ flood – with food, water, torches, batteries, warm blankets.
if not – also see: essential prepping supplies
If you liked this article - Please Share It
]]>